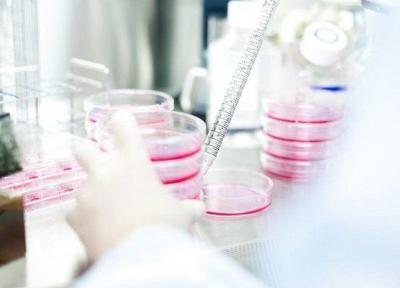

آخرین ارسال ها در وبلاگ های یومی بلاگ | صفحه 216

منتخبی از زیباترین تصاویر فضایی هفته منتشر شد
پایگاه خبری اسپیس منتخبی از تصاویر فضایی برتر روز های گذشته را منتشر کرد.

کاهش هزینه های تفریح در خانواده های ایرانی
خبرآنلاین: خانواده های ایرانی در سال 1394 ، با کاهش 10.2 درصد هزینه ناخالص سالانه خود را در امور تفریحی و فرهنگی روبرو شده اند.
مقایسه مدل شبکه متابولیک میان سلول های پرتوان بدن
به گزارش خبرنگاران، پرتوانی سلولها در بدن در دو سطح متفاوت مقدماتی (Primed) و خام (Naive) وجود دارد. سطح پرتوانی در سلول های پرتوان خام بالاتر است اما سلول های بنیادی پرتوان انسان که به طور معمول مورد استفاده قرار می گیرند، در حالت مقدماتی قرار دارند.

تخمین سوخت باقیمانده در زمین تا 2025
خبرگزاری مهر: زمین برای حرکات تکتونیکی، فعالیتهای آتشفشانی و عملکرد میدان مغناطیسی خود به سوخت نیاز دارد.

آموزش بهداشت عمومی و فردی تنها راه جلوگیری از شیوع آنفلوانزا
معاون امور بهداشتی دانشگاه علوم پزشکی یزد با اشاره به سرد شدن هوای استان، گفت: آموزش بهداشت عمومی و فردی، راه مراقبت از انتشار بیماری آنفلوانزا است.

چگونه از حالت Low Data در آیفون برای شبکه های موبایل و وای فای استفاده کنیم؟
اگر اصرار دارید از دیتای موبایل روی گوشی آیفون خود کمتر بهره ببرید؛ حالت Low Data در iOS 13 کاملا برای شما کاربردی و مفید است.

از همزاد تا شباهت های غیرعادی به سلبریتی ها! ، تصاویر
احتمالا آنطور که فکر می کنیم قیافه منحصر به فرد ،تک و مخصوص به خودمان نداریم!

بزوس ثروتمندترین فرد دنیا ماند
خبرنگاران: برخلاف ادعای بعضی رسانه ها، جف بزوس ثروتمندترین فرد دنیا باقی مانده است.

چهره های موسیقی ایران که مهاجرت کردند
وب سایت موسیقی ما - بهمن بابازاده: مهاجرت در حوزه موسیقی ایران پرونده غم انگیزی است. در این پرونده گاهی پیش می آمد که دست از تایپ بردارم و سراغ ترانه ها و قطعات چهره هایی بروم که در این گزارش به آن ها پرداخته شده و آثار قبل و بعد از مهاجرت شان را مقایسه کنم....

آمریکا علیه هوآوی اعلام جرم کرد
به گزارش خبرنگاران به نقل از بی بی سی، وزارت دادگستری آمریکا در اقدامی که به تشدید تنش ها با چین منجر خواهد شد؛ علیه شرکت هوآوی و منگ وانژو مدیر مالی آن اعلام جرم کرده و آنها را به سرپیچی از قوانین مالکیت معنوی و دروغگویی از بابت رعایت تحریم های ضدایرانی...

نقشه هایی که نگاهتان به دنیا را عوض می کند
خبرنگاران: دلیل اینکه برخی کشورهای بزرگتر یا کوچکتر از بقیه به نظر می رسند به دلیل چیزیست که تصویر مرکاتور نامیده می شود. آوردن یک سیاره سه بعدی روی یک نقشه دو بعدی برای نقشه نگاران اولیه نوعی چالش بود و بنابراین یک جغرافی دان و نقشه کش فلاندری به نام...

با پیشرفته ترین شهرهای تکنولوژیک دنیا آشنا شوید
وب سایت تکرا - زهرا جانعلیزاده: پیشرفته ترین شهرهای جهان از لحاظ تکنولوژی کدام ها هستند؟ در ادامه با آنها آشنا خواهیم شد. شهرها راستا حرکت به آینده هستند. بنا بر برآورد های سازمان بهداشت جهانی، تا 35 سال آینده، دو سوم جمعیت جهان در مناطق شهری زندگی خواهند...

بزرگترین تولیدکنندگان سویا در دنیا کدامند؟
سویا یکی از مهم ترین محصولات غذایی دنیا به شمار می رود که سال ها است در آسیا کشت می گردد. در این مقاله سعی داریم شما را با 10 کشور برتر تولیدکننده سویا در سطح دنیا آشنا کنیم. با خبرنگاران همراه باشید.

برترین تولیدکنندگان نیشکر دنیا کدامند؟
نیشکر محصولی مهم در سراسر جهان به شمار می رود که از جمله منابع اصلی تهیه شکر، اتانول و جیگِری نیز است. جیگری نوعی شکر نیمه تصفیه شده شبیه به قند است که در شبه قاره هند فراوری و مصرف می گردد. در ادامه با خبرنگاران همراه باشید تا برترین کشورهای فراوریکننده...

315 مقاله ISI دانشگاه لرستان در سال 97 منتشر شدند
مدیر پژوهشی دانشگاه لرستان گفت: 315 مقاله بین المللی ISI در سال 97 از سوی دانشجویان تحصیلات تکمیلی و اعضای هیئت علمی دانشگاه لرستان منتشر شده است.

چطور از خطرات جبران ناپذیر وای فای درامان بمانیم؟
خبرگزاری تسنیم: سازمان سلامت جهانی گزارشی منتشر نموده است که در آن به تشریح 10 اثر خطرناک و جبران ناپذیر امواج وای فای بر بدن انسان از جمله افزایش امکان ابتلا به سرطان، خنثی سازی اسپرم مردان و ناباروری در مردان و زنان پرداخته است.

این شهرها حرف اول را در تکنولوژی می زنند
وب سایت آی تی رسان: سازمان سلامت جهانی پیش بینی کرده که در کمتر از 35 سال، دو سوم از جمعیت جهان در روستاها و حاشیه شهر ساکن می شوند، جمعیتی 2.5 میلیارد نفری که به ساکنین فعلی زمین اضافه خواهند شد. شهر هایی که بیشترین رشد را در این بین دارند، آن هایی خواهند...

ماجراجویی در تو حالا مرا می بینی
جام جم: شرکت مستقل فیلم سازی سومیت اینترتینمنت به صورت رسمی خبر فراوری سومین قسمت تو حالا مرا می بینی را خاطرنشان کرد.

21 تیرماه، روز جهانی بدون پلاستیک
روزنامه فرهیختگان - نسرین نیکنام: آگاهی از مضرات باقی ماندن پلاستیک در طبیعت و تجدیدپذیر نبودن آن سبب شده که در سال های اخیر سازمان محیط زیست و شهرداری تهران کوشش نمایند با اجرای برنامه های فرهنگی گام هایی را برای کاهش استفاده از کیسه های پلاستیکی بردارند...

تازه ترین آمار درباره ثروتمندان ، یک درصدی که 54 درصد ثروت دنیا را در اختیار دارند
10 درصد از ثروتمندان دنیا معادل 82 درصد و یک درصد آنها معادل 45 درصد ثروت دنیا را در اختیار دارند. آمریکایی ها بیشترین ثروتمندان دنیا را دارند.